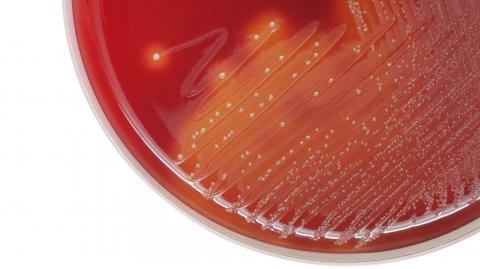
Streptococcus

Reaction to WHO report warning of rising antibiotic resistance in bacterial infections
The World Health Organisation (WHO) has published a report with data reported by 87 countries in 2020 warning of increasing antibiotic resistance in bacterial infections in humans. The report shows resistance levels of more than 50 % in bacteria that frequently cause bloodstream infections in hospitals, such as Klebsiella pneumoniae and Acinetobacter spp.

Dr Ghazaryan, head paediatrician at the Wigmore Clinic in Yerevan, Armenia, explains the importance of hand hygiene to her students. WHO / Nazik Armenakyan.
José Miguel Cisneros Herreros - OMS resistencia antibióticos 2022 EN
José Miguel Cisneros Herreros
Head of the Infectious Diseases Department at the Virgen del Rocío University Hospital in Seville
The report's conclusions are supported by increasingly good but still insufficient data. It is paradoxical that information on infections with multidrug-resistant bacteria is so poor at the international level considering the burden of disease that these bacteria cause.
Even so, they are sufficient, on the one hand, to highlight the extraordinary magnitude of the health problem that these infections represent and to justify the WHO's call for action. And on the other hand, to demonstrate once again the need for Microbiology laboratories in Spanish hospitals to operate 24 hours-7 days a week and the priority of creating the speciality of Infectious Diseases in Spain.
This report confirms previously published data, including this recent article: "Antimicrobial Resistance Collaborators. Global burden of bacterial antimicrobial resistance in 2019: a systematic analysis. Lancet 2022", which measures for the first time the global burden of these infections.